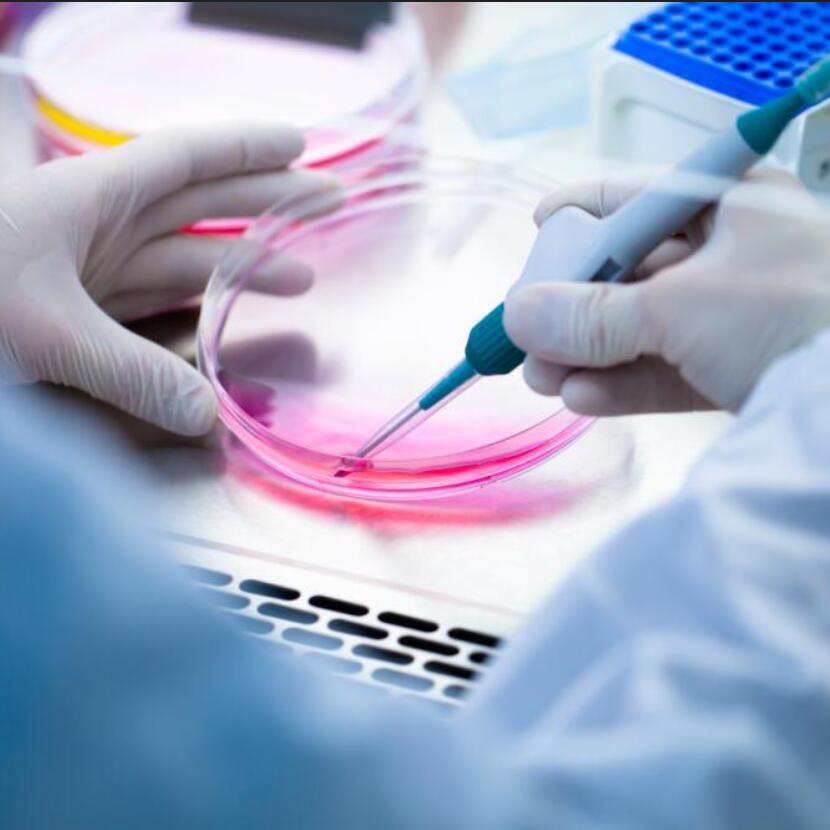

细胞培养步骤
2019/6/24
在进行细胞培养时,我们常用的仪器设备有:
无菌室,超净工作台,三重纯水蒸馏器,抽气泵,压力蒸气消毒器,电热恒温培养箱,培养器具,CO2培养箱,恒温水浴锅,倒置显微镜,离心机,无菌过滤器,洗刷装置,细胞计数板和电子细胞技术仪等等。
![]()
细胞培养的步骤过程,大致可分为以下几个环节:
1.准备工作
准备工作对开展细胞培养异常重要,工作量也较大,应给予足够的重视,推备工作中某一环节的疏忽可导致实验失败或无法进行。准备工作的内容包括器皿的清洗、干燥与消毒,培养基与其他试剂的配制、分装及灭菌,无菌室或超净台的清洁与消毒,培养箱及其他仪器的检查与调试。
2.取材
在无菌环境下从机体取出某种组织细胞(视实验目的而定),经过一定的处理(如消化分散细胞、分离等)后接入培养器血中,这一过程称为取材。如是细胞株的扩大培养则无取材这一过程。机体取出的组织细胞的首次培养称为原代培养。
理论上讲各种动物和人体内的所有组织都可以用于培养,实际上幼体组织(尤其是胚胎组织)比成年个体的组织容易培养,分化程度低的组织比分化高的容易培养,肿瘤组织比正常组织容易培养。取材后应立即处理,尽快培养,因故不能马上培养时,可将组织块切成黄豆般大的小块,置4℃的培养液中保存。取组织时应严格保持无菌,同时也要避免接触其他的有害物质。取病理组织和皮肤及消化道上皮细胞时容易带菌,为减少污染可用抗菌素处理。
3.培养
将取得的组织细胞接入培养瓶或培养板中的过程称为培养。如系组织块培养,则直接将组织块接入培养器皿底部,几个小时后组织块可贴牢在底部,再加入培养基。如系细胞培养,一般应在接入培养器皿之前进行细胞计数,按要求以一定的量(以每毫升细胞数表示)接入培养器皿并直接加入培养基。细胞进入培养器皿后,立即放入培养箱中,使细胞尽早进入生长状态。
正在培养中的细胞应每隔一定时间观察一次,观察的内容包括细胞是否生长良好,形态是否正常,有无污染,培养基的PH是否太酸或太碱(由酚红指示剂指示),此外对培养温度和CO2浓度也要定时检查。原代培养一般有一段潜伏期(数小时到数十天不等),在潜伏期细胞一般不分裂,但可贴壁和游走。过了潜伏期后细胞进入旺盛的分裂生长期。细胞长满瓶底后要进行传代培养,将一瓶中的细胞消化悬浮后分至两到三瓶继续培养。每传代一次称为“一代”。二倍体细胞一般只能传几十代,而转化细胞系或细胞株则可无限地传代下去。转化细胞可能具有恶性性质,也可能仅有不死性(Immortality)而无恶性。
4.冻存及复苏
为了保存细胞,特别是不易获得的突变型细胞或细胞株,要将细胞冻存。冻存的温度一般用液氮的温度-196℃,将细胞收集至冻存管中加入含保护剂(一般为二甲亚砜或甘油)的培养基,以一定的冷却速度冻存,最终保存于液氮中。在极低的温度下,细胞保存的时间几乎是无限的。复苏一般采用快融方法,即从液氮中取出冻存管后,立即放入37℃水中,使之在一分钟内迅速融解。然后将细胞转入培养器皿中进行培养。
冻存过程中保护剂的选用、细胞密度、降温速度及复苏时温度、融化速度等都对细胞活力有影响。
合肥知恩生物技术有限公司 版权所有 皖ICP备15022333号 免责声明